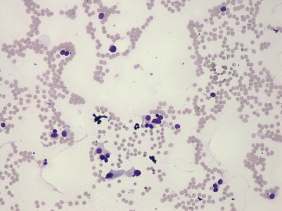

The role of complex diagnosis - follicular proliferation - Case 7. |
|
Clinical presentation: a 45-year-old woman requested a second opinion. She was evaluated in another hospital where hypothyroidism was diagnosed on clinical complaints. Ultrasonography described a "suspicious nodule" in the upper pole of the left thyroid from which cytology resulted in suspicion of follicular carcinoma and a total thyroidectomy was indicated.
Palpation: the thyroid was not palpable.
Hormonal examination: hypothyroidism with TSH 23.7 mIU/L.
Ultrasonography. The thyroid was hypoechogenic and atrophic. The left lobe was composed of hypoechogenic areas partly divided by connective tissue. There were no nodules of pathological sense in the thyroid.
Cytology was performed from the upper part of the left lobe. The cytological pattern corresponded to a microfollicular proliferation with significant atypia.
A combined clinical-ultrasound-cytological diagnosis was Hashimoto's thyroiditis and benign follicular proliferation and atypia caused by the dysfunction or the thyroiditis.
We told the patient that she harbors no nodule in which a carcinoma may occur and tried to talk her out of surgery. Thereafter she visited other endocrinologists, surgeon and finally decided to go on surgery.
A left lobectomy was performed. Histopathology disclosed Hashimoto's thyroiditis. No nodule was found.
Comment.
-
Microfollicles and microfollicular proliferation may be observed in each types of thyroid disorders. One of the well-known cytological pitfalls in Hashimoto's thyroiditis is even the deceptive follicular growth pattern.
-
To detect a discrete lesion on ultrasound is not equivalent to detect a nodule in a pathological sense. More than 90% of Hashimoto's cases present in the form of discrete echo abnormalities.
-
It is very hard, in most cases even impossible to resolve the fear from a carcinoma without histopathological analysis if a doctor states that the patient may harbor malignant disease. Every physician evaluating a patient has his or her own responsibility not cause unnecessary anxiety.
-
This patient's history again points at the need for a new approach in reporting system: to diagnose a follicular tumor without being aware of the clinical and ultrasound findings may lead to false diagnosis and unnecessary surgeries.